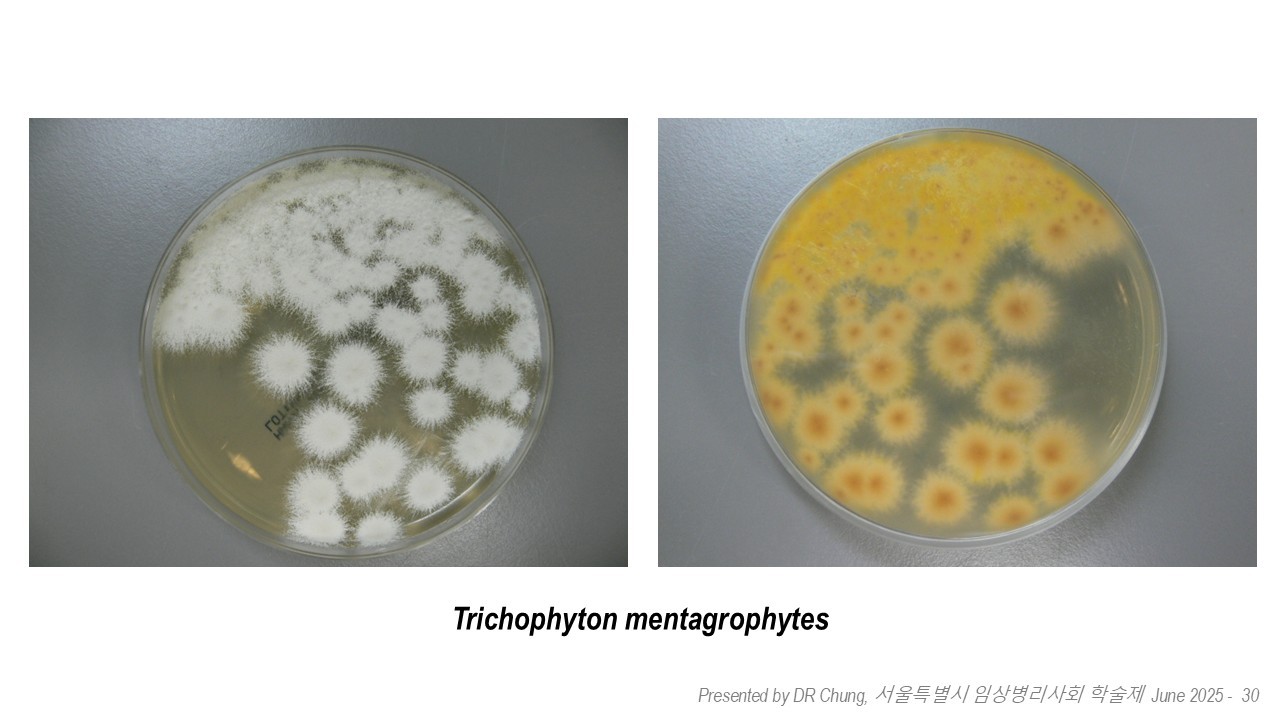
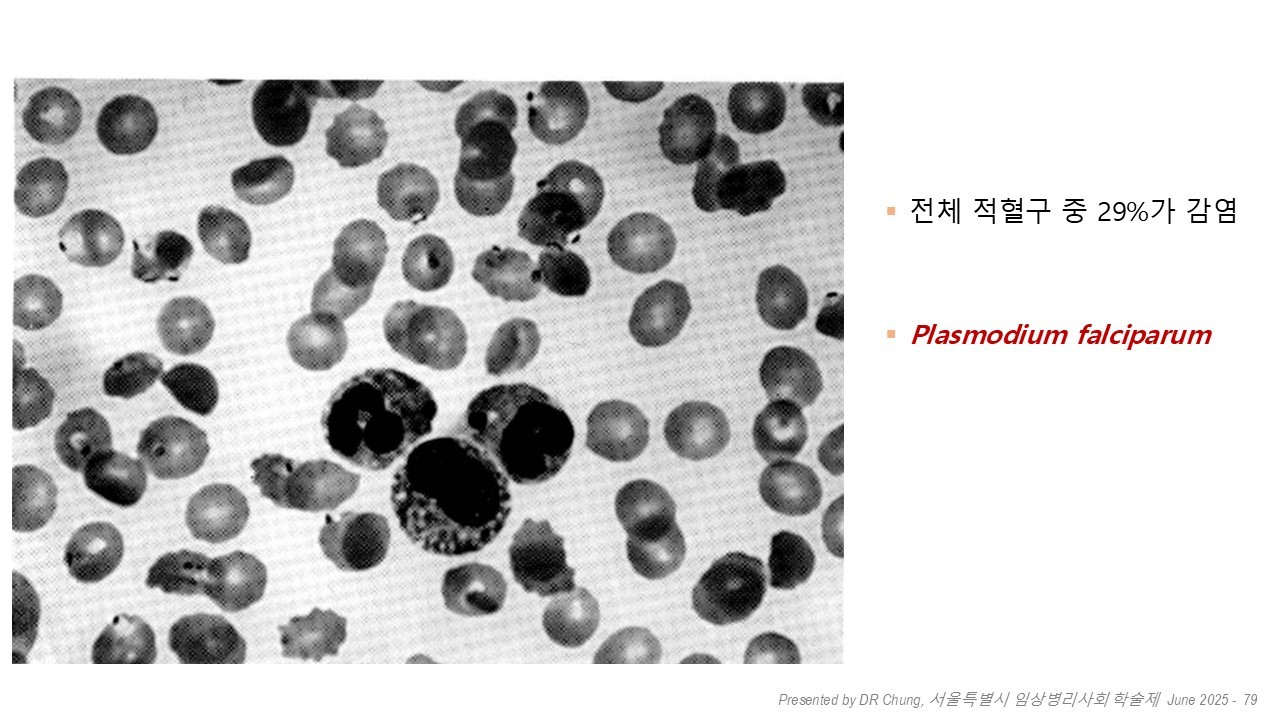

학술발표
추천: 임상병리사 모두
학술발표
추천: 임상병리사 모두
학술발표
추천: 임상병리사 모두
감염병 진단 현장에서의 임상병리 검사의 역할과 실제
감염병 진단 현장에서의 임상병리 검사의 역할과 실제
감염병 진단 현장에서의 임상병리 검사의 역할과 실제
감염병 진단 현장에서의 임상병리 검사의 역할과 실제

Contact us
Contact us
Contact us
여러분의 소중한 연구와 경험을 공유하여 임상병리사의 발전에 함께 기여해 주시길 바랍니다.
발표를 희망하시는 회원분께서는 언제든지 서울시 협회 학술부서로 연락주십시오.
여러분의 소중한 연구와 경험을 공유하여 임상병리사의 발전에 함께 기여해 주시길 바랍니다. 발표를 희망하시는 회원분께서는 언제든지 서울시 협회 학술부서로 연락주십시오.
여러분의 소중한 연구와 경험을 공유하여 임상병리사의 발전에 함께 기여해 주시길 바랍니다. 발표를 희망하시는 회원분께서는 언제든지 서울시 협회 학술부서로 연락주십시오.
여러분의 소중한 연구와 경험을 공유하여 임상병리사의 발전에 함께 기여해 주시길 바랍니다.
발표를 희망하시는 회원분께서는 언제든지 서울시 협회 학술부서로 연락주십시오.